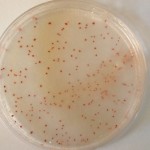
r2 cromog

R2A CROMOGENIC AGAR (A.P.H.A, Pharmacopea medio S, mejorado) permite obtener recuentos muy superiores de aerobios oligotrofos en aguas
Recuento total en aguas potables, con máxima recuperación , al continuar las células en un medio tan oligotrófico como la muestra de agua. Recomendado para recuento en aguas cloradas y farmacéuticas. La adición de un cromógeno termoestable permite el contraste de las colonias, rojas, con el color del medio con el de la membrana.
COMPOSICIÓN.
- Extracto de levadura 0,50 g
- Extracto de carne 0,50 g
- Hidrolizado de caseina 0,50 g
- Dextrosa-Glucosa 0,50 g
- Almidón soluble 0,50 g
- Di-K Hidrógeno Fosfato0,30 g
- Sulfato de Magnesio 0,024 g
- Piruvato de Sodio 0,30 g
- Mezcla cromogénica c.s.
- Agar-Agar 15,00 g
- (Fórmula por litro)
- pH final: 7,2 ± 0,2
PREPARACIÓN
Disolver 19 gramos de medio en 1 litro de agua bidestilada .
Agitar, calentando hasta ebullición,hasta la total homogeneización.
Autoclavar a 121 ºC durante 15 minutos. No sobrecalentar y enfriar rápidamente para evitar que el medio vire a rosa, lo que haría contrastar peor a las colonias rojas.
MANTENER EL BOTE BIEN CERRADO, EN LUGAR SECO, FRESCO Y OSCURO. AGITE EL BOTE ANTES DE USAR.
PARA USO EN LABORATORIO.
DESHIDRATADO CODIGO: DMT545
CONTROL DE CALIDAD DEL MEDIO
Realizado en nuestro laboratorio; es prudente repetirlo en su laboratorio siempre que varíen las condiciones (más de 3 meses sin usar, tras desinfectar laboratorio, tras conservar a alta Tª, cuando adquiere aspectos extraños aunque no haya llegado la fecha de caducidad teórica de la etiqueta,…)
DESHIDRATADO: Polvo grueso, Beige.
PREPARADO: Estéril, Blanquecino.
CONTROL DE CRECIMIENTO CUANTITATIVO 72 h a 37°C aproximadamente (o bien 5 días a Tª ambiente 21-28°C aproximadamente):
Escherichia coliMKTA 25922, Correcto, colonias rojas. Con respecto a PCA estandarizado*, recuento 132-161%
Enterococcus faecalisMKTA 29212, Correcto, colonias rojas. Con respecto a PCA estandarizado*, recuento 166-177 %
Pseudomonas aeruginosaMKTA 9027, Correcto, colonias rojas. Con respecto a PCA estandarizado*, recuento 85-143%
Staphylococcus aureus MKTA 6538P, Correcto, colonias rojas. Con respecto a PCA estandarizado*, recuento 111-133%
Aeromonas hydrophilaMKTA 49141, Correcto, colonias rojas. Con respecto a PCA estandarizado*, recuento >100%.
* El que cumple con recuperación superior al 92-125% con respecto a cepas cuantitativas trazables a la cepa tipo. Incertidumbres detectadas entre todos los lotes a lo largo de un año (la mayoría de la incertidumbre se debe a la cepa y a la proporción de cepas acompañantes inoculadas, no al medio).
PRESENTACIÓN: MEDIO DESHIDRATADO, FRASCOS PREPARADOS, PLAQUITAS HERMETICAS MF.
MODO DE EMPLEO E INTERPRETACIÓN DE RESULTADOS.
Inocular 1 ml en profundidad o mejor 0,1 ml en superficie, o aún mejor una membrana en superficie por la que se hayan filtrado 1-250 ml de muestra. Duplicar la muestra. Incubar una placa 5-7 días a 22 ºC aprox. para mesófilos y la otra 3 días a 30-37 ºC aprox. para termófilos. Contar todas las colonias, que serán rojas y muchas más que en medios normales como PCA, TSA, Nutrient Agar, LPT Neutralizing Agar… (Sanchís, 9/99, Interlaboratorio sobre la recuperación de medios nutritivos para recuento total en aguas, XVII Congreso S.E.M.). La flora termófila se asocia a procedencia humana. La mesófila al proceso de depuración. Este medio no es adecuado para recuento en alimentos, superficies o aire, sólo es mucho más sensible en aguas puras.
Si desea más información sobre nuestro R2 CROMOGENIC AGAR, rellene nuestro formulario de contacto http://www.medioscultivo.com/contacto . O si lo prefiere póngase en contacto con nosotros a través de nuestro correo electrónico microkit@microkit.es o por teléfono en el nº 91-897 46 16
Mejora del R2A para el recuento de aerobios en aguas oligotróficas
https://www.microkit.es/fichas/CROMOKIT-R2-AGAR.pdf
Prepárese para más de una sorpresa informativa cuando vea nuestro video: https://youtu.be/qE2gNZH9KWQ?si=sAKHe8KqtGkBua9V
